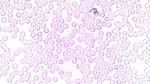
ارتفاع عدد كريات الدم البيضاء
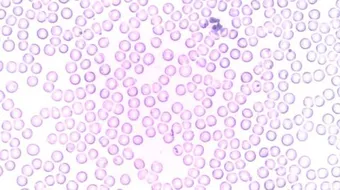
ارتفاع عدد كريات الدم البيضاء

ارتفاع عدد كريات الدم البيضاء
ارتفاع عدد كريات الدم البيضاءتُعدّ خلايا الدم البيضاء (بالإنجليزية: White blood cells) جزءاً مهمّاً من الدم، إذ تكمن وظيفتها في المقام الأول في الدفاع عن الجسم
ارتفاع عدد كريات الدم البيضاء
تُعدّ خلايا الدم البيضاء (بالإنجليزية: White blood cells) جزءاً مهمّاً من الدم، إذ تكمن وظيفتها في المقام الأول في الدفاع عن الجسم ضد العدوى والأمراض المختلفة، وإنّ لخلايا الدم البيضاء خمسة أنواع مختلفة، هي الخلايا اللفاوية، والخلايا القاعدية، والخلايا الوحيدة، والخلايا المتعادلة، والخلايا الحمضية، وفي الحقيقة يتمّ إنتاج هذه الخلايا من قبل نخاع العظم، ويُقدّر إنتاج الجسم لهذه الخلايا في اليوم الواحد ما يُقارب مئة مليار خلية، وذلك لأنّ لهذه الخلايا دورة حياة، فبمجرد انتهائها يجب أن تحل خلايا جديدة مكانها، وعلى الرغم من اختلاف عدد كريات الدم البيضاء في الوضع الطبيعي من شخص إلى آخر، وخاصة بين الأشخاص الذين ينتمون لأعراق مختلفة، إلا أنّ العدد بشكل عام يتراوح ما بين 4000-1000 خلية في الميكرولتر الواحد من الدم، وإنّ زيادة عددها عن هذا المُعدّل يُعرف بارتفاع كريات الدم البيضاء (بالإنجليزية: Leukocytosis).[1]
أسباب ارتفاع عدد كريات الدم البيضاء
يمكن أن يرتفع عدد خلايا الدم البيضاء نتيجة فرط إنتاج الجسم لها لمحاربة عدوى معينة، أو بسبب تفاعل نتيجة تناول أخذ دواء معين، أو بسبب إصابة نخاع العظم بمرض يُحفّزه لإنتاج خلايا الدم البيضاء بعدد يفوق الحد الطبيعيّ، وكذلك يمكن أن تحدث زيادة في عدد خلايا الدم البيضاء بسبب اضطراب مناعيّ، ويمكن بيان الأمثلة على الأسباب سالفة الذكر فيما يأتي:[2]
- سرطان الدم الليمفاوي الحاد (بالإنجليزية: Acute lymphocytic leukemia).
- تفاعلات الحساسية.
- سرطان الدم اللمفاوي المزمن.
- تناول بعض أنواع الأدوية مثل: الكورتيكوستيرويدات (بالإنجليزية: corticosteroids).
- السعال الديكي (بالإنجليزية: Whooping cough).
- السل.
- التدخين.
- التهاب المفاصل الروماتيديّ.
- التعرض للتوتر العاطفي أو الجسدي الشديد.
علاج ارتفاع عدد كريات الدم البيضاء
يعتمد علاج ارتفاع عدد كريات الدم البيضاء على المسبب، ومن الخيارات العلاجية المتاحة ما يأتي:[3]
- المضادات الحيوية إذا كان المُسبّب هو العدوى.
- مضادات الحساسية لعلاج تفاعلات التحسس.
- تغيير الدواء المُسبّب لارتفاع كريات الدم البيضاء إن أمكن.
- العلاج الكيماوي، أو الإشعاعي، أو زراعة نخاع العظم إذا كان السبب هو الإصابة بسرطان الدم.
المراجع
- ↑ "What to know about high white blood cell count", www.medicalnewstoday.com, Retrieved May 11, 2019. Edited.
- ↑ "High white blood cell count", www.mayoclinic.org, Retrieved May 11, 2019. Edited.
- ↑ "What Is Leukocytosis?", www.healthline.com, Retrieved May 11, 2019. Edited.
المقال السابق: ارتفاع الهيموجلوبين في الدم
المقال التالي: لعلاج الحموضة في المعدة
ارتفاع عدد كريات الدم البيضاء: رأيكم يهمنا
0.0 / 5
0 تقييم
